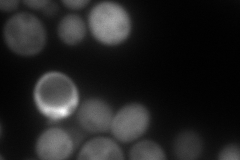

View description
Maltase (alpha-D-glucosidase), inducible protein involved in maltose catabolism; encoded in the MAL3 complex locus; functional in genomic reference strain S288C
Localization:
Intensity:
Fold change:
Significance:
-
C’ GFP library in SD

below threshold17.04 -
N' NOP1pr-GFP in SD

cytosol221.669 -
N' TEF2pr-mCherry in SD
cytosol164.483 -
N' NATIVEpr-GFP in SD

below threshold14.1048 -
N' TEF2pr-VC and Cyto-VN in SD

#N/A0 -
C’ GFP library in SD+DTT

cytosol16.520.96No -
C’ GFP library in SD+H2O2

cytosol18.021.05No -
C’ GFP library in Starvation Media

cytosol15.770.92No -
C’ GFP library on the background of Pup2-DaMP

below threshold -
C’ GFP library on the background of CCT mutant

below threshold19.15891.12325No
